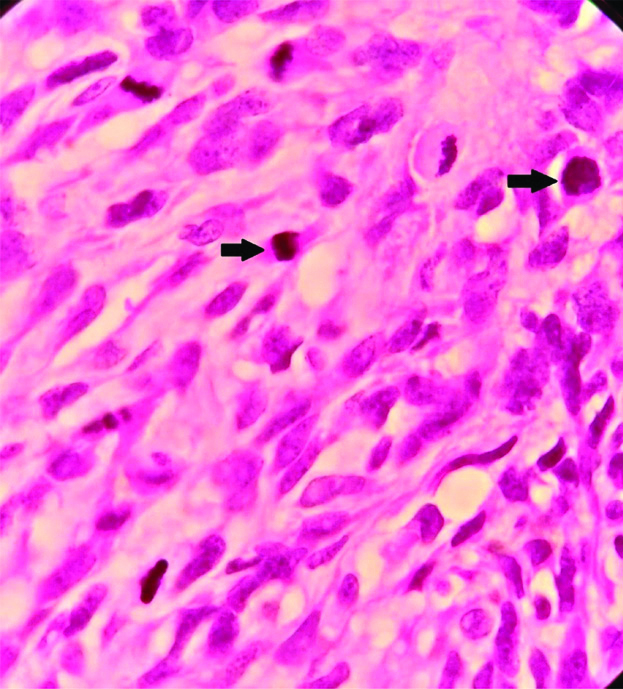

The GIST is the most common mesenchymal neoplasm of the alimentary canal and accounting to 0.1-3% of all malignant tumours of Gastrointestinal Tract (GIT) [1]. GIST can occur anywhere in the GIT. Many studies have proven that the most common site of GIST is the stomach followed by the small intestine, colon, rectum and oesophagus. The cell of origin of GIST was a matter of debate over a long period of time. Now, interstitial cells of Cajal are believed to be the cell of origin of GIST [2].
The malignant behaviour of GIST cannot be predicted by usual characteristics like pleomorphism and necrosis. Specific criteria based on site, size and mitotic rate have been established to predict the biological behaviour of tumour like recurrence and metastasis [3]. GIST can be differentiating from other mesenchymal tumours of GIT with the help of Immunohistochemistry (IHC). The discovery of CD117 positivity and the presence of c-kit mutations defined GIST as a specific mesenchymal neoplasm and a separate clinicopathological entity [4].
The treatment of GIST has being revolutionised by the discovery of targeted therapy with tyrosine kinase inhibitors, hence an accurate diagnosis of GIST became mandatory [5]. But a small group of GISTs, especially those with Platelet Derived Growth Factor Receptor-Alpha (PDGFRA) mutation stain negative for CD 117 but can still benefit from tyrosine kinase inhibitors. In addition, some GISTs showing low CD117 expression by IHC will also respond to tyrosine kinase inhibitors [6].
The identification of PDGFRA mutation is a costly process and cannot be done routinely. Moreover, resources for molecular analysis are available only in a very few selected hospitals in the country. Discovered On GIST-1(DOG-1) becomes a very useful marker in such cases. It is said to be more sensitive and specific than CD 117 and is known to stain atleast 50% of CD 117 negative GISTs [7]. Appendix can serve as positive and negative tissue control for DOG1. A moderate-to-strong predominantly membranous staining must be seen in virtually all Cajal cells, whereas a weak staining reaction must be seen in basal columnar epithelial cells, scattered endothelial and smooth muscle cells of blood vessels. No staining reaction should be seen in mast cells and smooth muscle cells of muscularis propria and lamina muscularis mucosae. Desmin is a muscle specific protein and is one of the intermediate filaments constituting the cytoskeleton. In normal tissue, not only smooth muscle cells but also striated muscle cells are positive for desmin. Therefore, leiomyomas are basically positive for desmin, on the other hand, GIST’s and neurogenic tumours are commonly negative for desmin. The present study aimed to categorise each case of GIST into its appropriate risk category and to find out whether any histopathological parameter studied has significant association with the risk group. The present study also aimed to compare the older IHC marker, CD 117 against the newer IHC marker DOG-1 to bring out a better management plan for the patient.
Materials and Methods
A hospital-based cross-sectional study of 108 histopathologicaly confirmed resected GIST specimens were taken between the time period of January, 2017 to December, 2019 in the Department of Pathology, Vydehi Institute of Medical Sciences and Research Centre (VIMS&RC), Bangalore. Only confirmed cases were conclused bold ex-Ethical clearance for the study was obtained from the Institutional Ethics Committee (VIEC/2017/APP/147). Other mesenchymal tumours, needle biopsies and cytology materials were excluded from the study. In these cases, distribution according to age, sex, tumour location, size, mitotic counts in 50/HPF, atypia, mucosal invasion, necrosis, haemorrhage, myxoid change, perinuclear vacuoles, multinucleation, inflammation and skenoid fibres were evaluated. In addition IHC analysis was performed. Desmin, CD 117 and DOG-1 staining were quantitatively evaluated. The cases were classified according to the Fletcher’s risk classification as very low, low, intermediate and high risk according to the tumour diameter, mitotic count, age and tumour site [8].
Immunohistochemistry
The IHC evaluation of the markers CD117, DOG-1 and Desmin was performed on representative histologic sections. Antigen retrieval was done by pressure cooker method and distilled water wash was given. Peroxidise and power blocks were done followed by buffer wash.
Power (protein) block of 100 microliter was done and primary antibody was applied for an hour and washed with Tris-Buffered Saline (TBS). Then, super enhancer (postprimary) was added, for 30 minutes. Subsequently, secondary antibody i.e., polymer Horseradish Peroxidase (HRP) 100 microliter was applied for 30 minutes, followed by washing with TBS. Then, freshly prepared Diamine Benzidine (DAB) chromogen was applied for 10 minutes. Counter staining was done with Mayer’s Haematoxylin followed by clearing and mounting. Appendix was used as positive and negative tissue controls for CD117 and Desmin and a monoclonal antibody to DOG1(Clone 1.1) was used.
Statistical Analysis
Chi-square test with Yates correction was used to calculate p-value to ascertain statistical significance. It was done to assess the strength of association of age, tumour site, tumour size and mitosis. A p-value of <0.05 was considered statistically significant. The master chart of collected data was prepared in Excel Sheet. Descriptive statistical analysis was presented in the form of tables, figures and diagrams wherever necessary using Epi info 07 statistical software package.
Results
In the present study, majority of the study population were in the ≤50 years age group depicted in [Table/Fig-1], with a mean age group of 55.6±14.4 years and the female-to-male ratio being 4:5. The mean tumour size was 9.1±5.8 cm, ranging from 1.5 cm to 25 cm. Majority of the tumours were located in small intestine (48 cases/44.4%) followed by stomach (39 cases/36.1%), three cases of retroperitoneal GIST (2.8%) and 18 cases (16.7%) were metastatic GIST detected in liver with more than six years of disease free period. Spindle cell morphology was found in 86.1% of the cases (93 cases) followed by epithelioid cell type in 12 cases (11.1%) and mixed morphology in three cases (2.8%). A total of 54 cases (50%) came under the high risk, ten cases (9.2%) came under the very low risk, 32 cases (29.6%) under low risk and 12 cases (11.1%) were categorised under intermediate risk group depicted in [Table/Fig-2].
Age distribution of cases.
| Age in years | No. of cases | Percentage |
|---|
| ≤50 | 42 | 38.9 |
| 51-60 | 27 | 25 |
| 61-70 | 24 | 22.2 |
| ≥70 | 15 | 13.9 |
| Total | 108 | 100.00 |
Percentage distribution of the sample according to risk.
| Risk group | No. of cases | Percentage (%) |
|---|
| Very low risk | 10 | 9.2 |
| Low risk | 32 | 29.6 |
| Intermediate risk | 12 | 11.1 |
| High risk | 54 | 50 |
| Total | 108 | 100.00 |
Out of 108 cases analysed, 102 cases (94.4%) shows low to moderate atypia, 63 cases (58%) showed haemorrhage, 60 cases (55.6%) showed inflammation, 5 cases (4.7%) showed necrosis, 36 cases (33.3%) showed myxoid change, 33 cases (30.6%) had perinuclear vacuoles, nine cases (8.3%) had skenoid fibres, six cases (5.6%) had multinucleation and mucosal invasion. Out of the nine variables analysed, only necrosis was found to have significant association with high risk group. A total of 63 cases (58.4%) of cases shows ≤5 mitosis/50 HPF and 45 cases (41.6%) of the cases showed >5 mitosis/ 50 HPF. Atypical mitotic figures are depicted in [Table/Fig-3]. A total of 97 cases (90%) of the tumours with size less than five cm was in the low risk category. A total of 59 cases (54.5%) tumours with the size in the range of 5-10 cm and 95 cases (87.5%) with size of >10 cm were in high risk category. A total of 101 cases (93.3%) of the tumours in the high risk category had >5 mitosis per 50 HPF concluding that the tumour size >5 cm and mitotic rate >5/50 HPF are indicators of worse prognosis.
Microphotograph depicting atypical mitosis (H&E, X 1000).
Immunohistochemical markers used to confirm the histopathological diagnosis in this study included CD117, DOG-1 and Desmin. CD117 is considered as a good diagnostic marker of GIST’s. The staining patterns of CD117 in GISTs can be diverse and includes cytoplasmic, membrane and paranuclear or golgi pattern, even though CD117 is very useful in the diagnosis. 5-10% of GISTs are CD117 negative. On immunohistochemical analysis 90 cases (83.3%) cases showed positivity for CD 117, 96 cases (88.9%) cases were positive for DOG-1 and all the 108 cases (100%) cases were negative for Desmin [Table/Fig-4]. Desmin was used to exclude the smooth muscle neoplasms and all 108 cases included in this study was negative for desmin. The sensitivity and accuracy of CD117 was 83.3%, positive predictive value was 100% and false negative value was 16.7. When CD 117 and DOG-1 were compared, DOG-1 was found to be more sensitive and accurate (88.9%), with a positive predictive value of 100% and a false negative value of 11.1.
a) Microphotograph depicting spindle cell GIST (H&E, X 400); b) Desmin negativity in spindle cell GIST (Desmin, X 400).

Discussion
GISTs belong to a heterogeneous group of tumours with different morphological features and varied biological behaviour [8]. The socio-demographic variables of present study showed a mean age of cases as 55.6±14.4 years which is in concordance with a study done by Din NU et al., where the mean age was 51 years and the age of the patients ranged from 16 to 83 years [9].
Out of the 108 cases, 60 patients were males (55.6%) and 48 patients were females (44.4%). The male preponderance found in present study was similar to the results in the study conducted by Lerma E et al., [10]. A study done by Tran T et al., also found similar percentage of affected males and females [11].
One of the factors used to predict the risk of either recurrence or metastasis in GISTs is the size of the tumour. The mean tumour size of the present study was 9.1±5.8 cm and the median was 7.8 cm which corresponds to the study conducted by Vij M et al., where the median and the mean tumour size were 9 and 10.71 cm, respectively [12].
Tumour size is another parameter used in the risk analysis of GISTs. In present study, maximum cases were located in the small intestine (44.4%) which was is in discordance with a study conducted by Abdel-Hadi M et al., wherein maximum number of cases of GISTs was in the stomach (61.6%) [13]. Small intestinal GISTs are said to be more aggressive than the GIST found at other sites.
The commonest histological cell type found in present study was spindle cells and was in 93 cases out of 108 (86.1%). This is supported by the study done by Steigen S et al., where they found the commonest histological type as spindle type [14]. This is also in concordance with the observations of Kim KM et al., [15].
In the present study, 63 out of 108 cases had a mitosis of ≤5/50 HPF (58.4%). This conclusion is substantiated by the study done by Poveda A et al., where they report that the majority of GIST shows a low mitotic count i.e., ≤5/50 HPF [16].
Histopathological parameters for analysis included nuclear atypia, necrosis, haemorrhage, myxoid change, inflammation, mucosal invasion, perinuclear vacuoles, multinucleation and skenoid fibres. Strength of association of all the above parameters to the risk groups were analysed using Chi-square test. The only histological parameter which had significant association with high risk category was necrosis (p-value 0.016). This observation was identical to the finding of Oliveria RP et al., and Hou YY et al., wherein they found necrosis was associated with poor prognosis [17,18]. Necrosis is considered to be directly proportional to the proliferative activity of tumour and so the most aggressive tumours will present with necrosis.
Present study did not find any significant association between high risk groups and mucosal invasion or presence of myxoid change. Mucosal infiltration or invasion is defined as tumour cells breaching the muscularis mucosae and extending into the lamina propria. Trupiano JK et al., observed significant association between mucosal invasion and myxoid background with advanced outcome of GIST [19]. This discordance in the observation may be due to lesser sample size of the present study.
Multifocality was another finding that was analysed in this study and we found a significant association between this and the high risk groups (p-value 0.033). Multifocal lesions were seen in 77.8% cases of high risk GISTs whereas only 22.2% low to intermediate risk GISTs had multifocality as depicted in [Table/Fig-5]. Klieser E et al., also established significant association between multifocality and survival in his study [3].

Out of the four variables, i.e., age, tumour size, tumour site and mitosis, tumour size and mitosis were found to have significant correlation with the risk groups (p-value 0.004 and <0.001, respectively) wherein our present study concluded that the tumour size >5 cm and mitotic rate >5/50 HPF were indicators for poor prognosis. Similar results were observed in a study done by Fletcher CD et al., [20].
The accuracy and sensitivity of CD117 and DOG-1 in the present study which correlated with the observations of Krishnappa P et al., and Sun XW et al., respectively [21,22]. Present study results of DOG-1 positivity in CD117 negative GIST are almost similar to the findings of Lee C et al., [Table/Fig-6,7] [23].
a) Microphotograph depicting submucosal location of GIST (H&E, X 100); b) DOG-1 positivity in the submucosal lesion (DOG-1, X 100).

a) Microphotograph of epithelioid GIST with prominent cytoplasmic clearing and signet ring shaped cells (H&E, X 400); b) CD117 positivity in epithelioid GIST (CD117, X 400).

Limitation(s)
Since the study was done in histologically-proven GIST cases, specificity of IHC markers could not be analysed.
Specificity signifies true negative cases. If we had taken all spindle cell neoplasms in the GIT, specificity can be given. As it was done on histologically proven GIST cases, specificity can not be determined.
Conclusion(s)
In view of increasing incidence of GIST in this modern era and with availability of targeted therapy, diagnosis of the disease accurately is very important. Risk categorisation of GIST remains important even with the advent of more specific IHC markers and molecular testing for a better understanding of its biological behaviour. This study found significant association of high risk group with tumour size, multifocal lesions, necrosis and mitosis >5/50 HPF. A combination of CD117 and DOG-1 will be more useful in diagnosing GIST rather than using them alone.